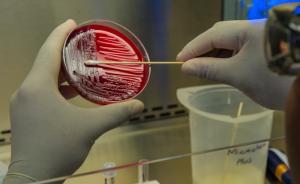
Food Science 4

Undergraduate Programmes
Students can, depending on their existing qualifications, join following degrees:
- BSc Food Science
Programme information
For complete information on the programme/degree structure, subject choices and application procedures, please refer to University of Stellenbosch yearbook for the Faculty of AgriSciences.
General Enquiries

Undergraduate Admission Requirements
BSc Food Science
- NSC or IEB aggregate of at least 5 (60%) Excluding Life Orientation
- English or Afrikaans (Home Language or First Additional Language) 4 (50%)
- Mathematics 5 (60%)
- Physical Sciences (Physics & Chemistry) 4 (50%)
Admission requirements may differ on an annual basis.
Please refer to the yearbook for module codes
Please note that Food Science is a selection course and only a certain number of students can be accommodated annually.
Programme Structure
First Year
- Biology
- Chemistry
- Physics
- Computer skills
- Mathematics
- Introduction to Food Science
Second Year
- Biochemistry
- Biometry
- Chemistry
- Microbiology
- Food processing and preservation
Third Year
- Food Biochemistry
- Food Chemistry
- Microbiology
- Meat Science
- Nutrition
- Food Safety
- Cereal Science
- Sensory Science
Fourth Year
- New Product Development
- Food Chemistry and Analysis
- Food Process Engineering
- Food Packaging
Applications
- Opens around 1 April, closes 31 July annually
- Apply with your Grade 11 end of the year results (if in Grade 12)
- Apply with your Grade 12 end of the year results (if already matriculated)
- Apply at www.maties.com
- Can apply for 3 programmes (either in 3 different faculties or 3 programmes in the same faculty)
- Applicants will be considered for all 3 programmes and can get conditional offers for all 3 programmes
- Applicants need to choose one programme they wish to study and accept the conditional offer
- They do not have to wait to get all 3 offers to accept one, they can accept one and if at a later stage they get another, they can decline the first one they got and accept the 2nd offer
- Students need to meet the requirements again based on their final Grade 12 results and will then get a final offer they need to accept
- Please note that students receive an Application ID (App ID) and only later a student number
